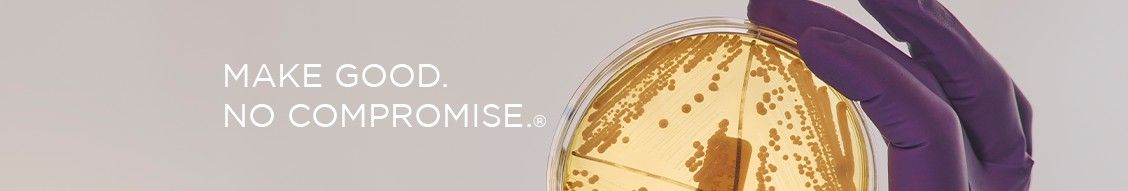

All categories Energy & power Amyris Inc
Emeryville, California, United States
Amyris, Inc. is at the forefront of sustainable innovation, leveraging synthetic biology to create renewable ingredients that address global environmental and health challenges. By designing and producing high-performance molecules, Amyris serves industries such as beauty, health, food, and clean energy with eco-friendly alternatives to traditional ingredients. Amyris’s proprietary technology platform enables precision fermentation, reducing reliance on fossil fuels and minimizing waste. Its diverse portfolio includes partnerships with leading brands and the production of consumer goods under its own labels, showcasing the versatility and impact of its solutions. Driven by a mission to accelerate the world’s transition to sustainability, Amyris focuses on reducing carbon footprints, conserving biodiversity, and delivering high-quality products. The company's dedication to innovation and transparency makes it a trusted partner for organizations seeking impactful, science-backed solutions for a greener future.
Operating since 1200
1500 Members
Found any error in information about this organisation?
Are you owner of Amyris Inc?
Similar companies
Bison Roofing and Solar
Fort Lauderdale, Florida, United States
Bison Roofing and Solar specializes in roofing and solar solutions, offering exceptional craftsmanship and energy-efficient installations. Their services prioritize durability, aesthetics, and sustainability, helping clients lower energy costs while protecting their property. With a commitment to quality and customer satisfaction, Bison ensures every project is tailored to individual needs.

180 Solar Power, Inc.
Escondido, California, United States
180 Solar Power is a family-owned solar contractor based in Southern California. With over 30 years of experience and more than 2,000 installations, they specialize in solar and battery storage solutions for homes and businesses. Their services help customers gain energy independence and reduce reliance on utility companies.

BluEarth
Calgary, Alberta, Canada
BluEarth Renewables is a leading renewable energy company specializing in the development, construction, and operation of wind, solar, and hydroelectric projects. With a strong commitment to sustainability and community engagement, BluEarth provides clean energy solutions that reduce carbon footprints, promote environmental stewardship, and contribute to a greener, more sustainable future.
ecoligo
Berlin, Berlin, Germany
Ecoligo is at the forefront of the renewable energy revolution, offering a groundbreaking crowdfunding platform that connects socially and environmentally conscious investors with sustainable projects in emerging markets. Their primary focus is on financing solar projects, which not only reduce carbon emissions but also drive economic growth in underserved regions. Through Ecoligo's platform, investors can contribute to the expansion of clean energy infrastructure while enjoying competitive returns on their investments. This innovative approach not only supports the transition to sustainable energy sources but also empowers local communities by creating jobs and reducing energy costs for businesses. Ecoligo's mission embodies the dual goals of environmental stewardship and economic development, making it a pivotal player in the global sustainability movement.

Solarkiosk Solutions
Berlin, Berlin, Germany
Solarkiosk Solutions delivers modular, solar-powered infrastructure to off-grid communities, fostering sustainable economic and social development. Their E-HUBB technology provides energy, connectivity, and essential services, empowering local businesses and improving lives in underserved regions across Africa, Asia, and beyond.